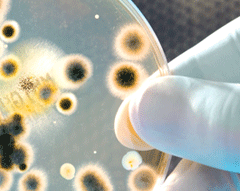

AHCC®의 과학
임상을 통해 검증된, 혁신적인 고품격 성분

AHCC®(Active Hexose Correlated Compound)는 일본 최고의 건강식품중 하나로, 세계적으로 수십 번 이상의 임상실험을 통해 검증된, 면역에 도움을 주는 성분입니다.
퍼브메드에 수많은 연구자료가 등재되어 있고, 수백 편의 실험 연구가 진행되었습니다.
AHCC®는 효과적이고 잘 흡수되며, 분자량이 5,000달톤 정도로 작은 분자구조를 가진, 알파글루칸이 다량 함유된 버섯 균사체 입니다.

 미국사이트가기
미국사이트가기